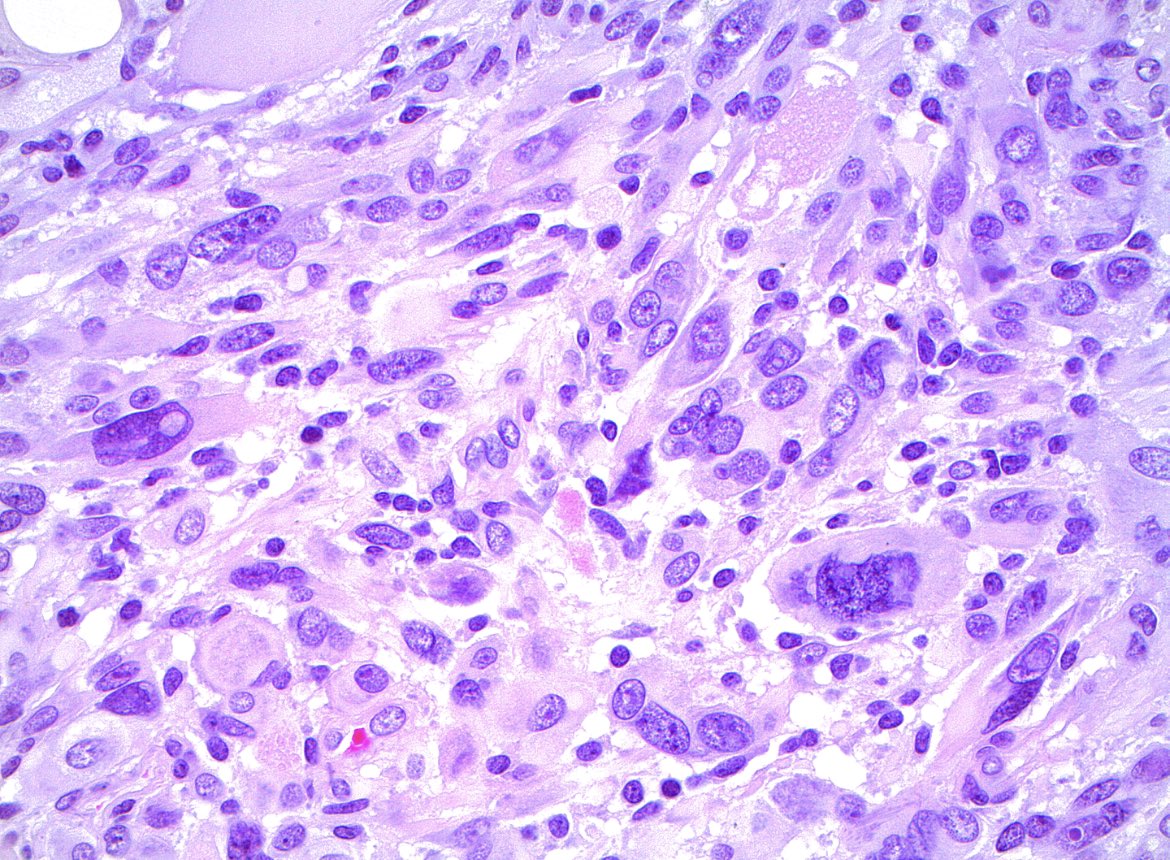
Jared T. Ahrendsen MD, PhD (AP/NP/FP) tweet media

🔬 The second paper from our new Practice Essentials series is now available! This edition, led by Manon Auger MD of @mcgillu, presents a practical approach to follicular neoplasm (FN) and its subtype oncocytic FN. acsjournals.onlinelibrary.wiley.com/doi/full/10.10… #CytoPath #ENTPath #BethesdaSystem